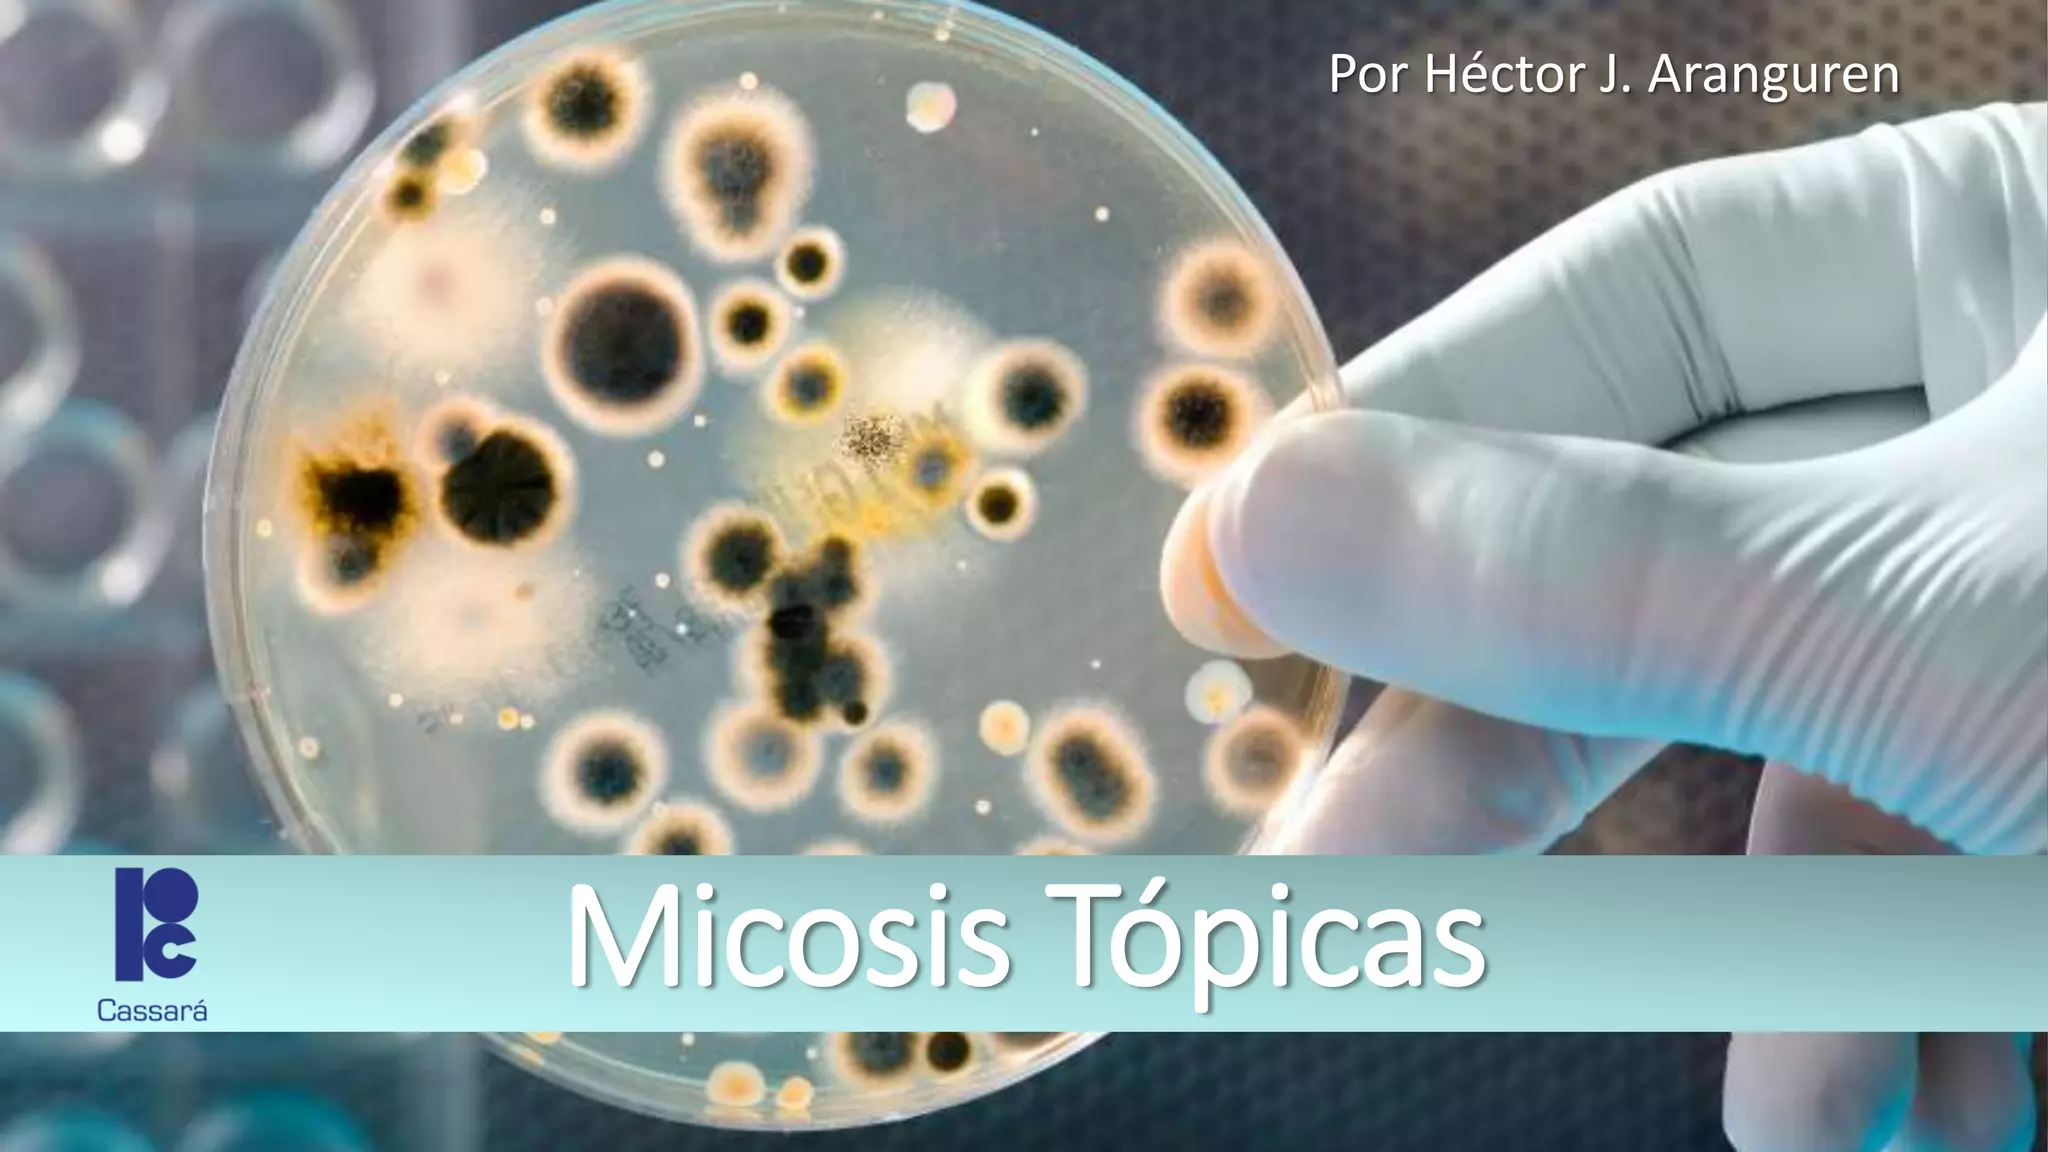

Este documento describe las micosis tópicas, infecciones de la piel causadas por hongos. Los síntomas varían según la ubicación y pueden incluir placas escamosas, eritema o pústulas en el cuero cabelludo, barba, cuerpo o pies. El tratamiento incluye antimicóticos tópicos como ciclopirox olamina o clotrimazol para casos leves y limitados, o tratamiento oral con itraconazol o terbinafina para infecciones más extensas.